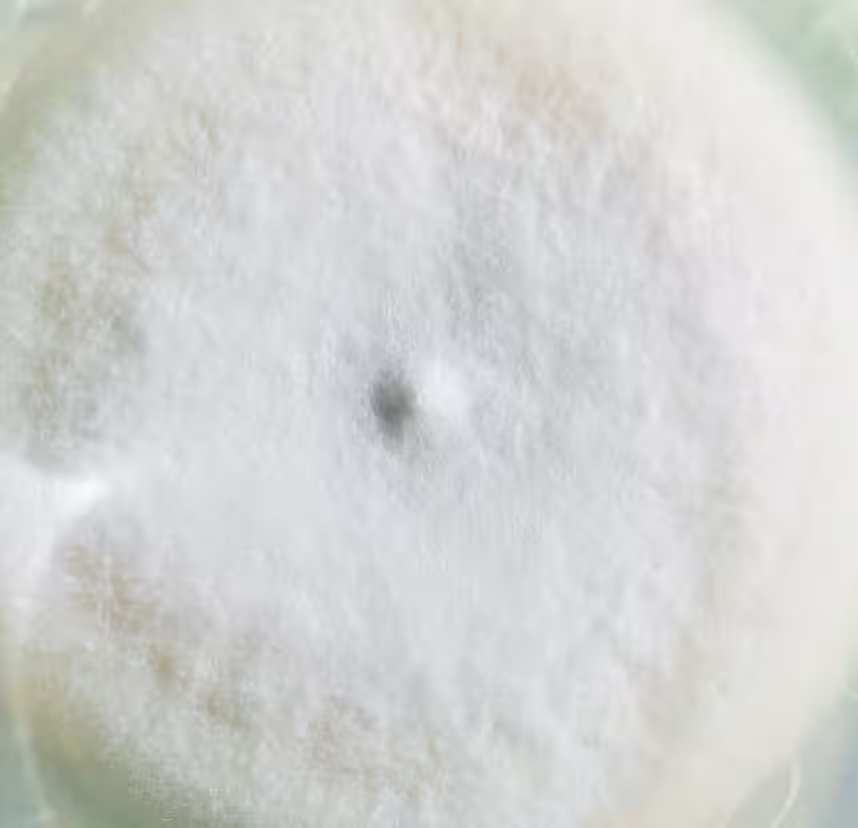
画像3

新たな学びの場「TanKen」がつくばで始動!子どもの好奇心を育む実験教室
新たな学びの場「TanKen」がつくばに登場
2025年9月、茨城県つくば市に新しい子ども向け実験教室「TanKen」が開設されることが決まりました。「TanKen」とは、「探究」や「研究」をテーマにした参加型のプログラムが展開される場所で、子どもたちが自らの好奇心を活かして学びを深めることを目指しています。
研究者の視点から学びを提供
「TanKen」では、子どもたちが「研究者見習い」としてプログラムに参加し、実際に手を動かして実験や観察を行うことで、より深い学びを体験します。単なる知識の習得だけではなく、未知の現象に対する好奇心や自発的な探求心を育むことが重要視されています。
このような姿勢は、個々の子どもたちが「探究者」として未来を切り拓く力を養い、社会とつながる土台を築くことにもつながります。子どもたちが自ら問いを立て、発見していく力を育むことで、答えのない問いに向き合う力を育てることは、現代社会においてますます重要な要素となってきています。
「TanKen」が誇る3つの特徴
「TanKen」のプログラムには、以下の3つの特徴があります。
1. 実験を通じた学び
実際に手を動かすことで、「観察」「予想」「実験」「振り返り」のサイクルを実現。これにより、体験から得る知識が重視される。
2. 多彩な研究テーマ
微生物や昆虫、陶芸など、様々な分野のテーマが取り上げられ、プログラムは各分野の専門家によって監修されます。これにより、より専門的な知識と経験を得た指導が受けられます。
3. 少人数・対話型の授業
8名程度の少人数で行われる授業では、一人ひとりの発見や疑問を尊重し、対話を通じて深い学びを進めることができます。
プログラム概要
「TanKen」は9歳から15歳までの子どもたちを対象に、毎週水曜日の17:00から18:30までの時間帯で開催されます。月謝は15,000円(税別)で、プログラムは2ヶ月ごとに編成されます。
会場はつくば市吾妻1-10-1のつくばセンタービル1F co-en内です。
未来を見据えたプログラム内容
「TanKen」では、実験を通して考える楽しさを提供する多様なテーマのプログラムが準備されています。たとえば、微生物や昆虫の生態系を探るプログラムでは、「小さな命は、どんな戦略で生きのびている?」という問いにチャレンジし、寄生蜂の生き様を観察します。その他にも、未来の食卓を考える「未来の食卓には、どんな菌肉が並ぶ?」や、「世の中の「美しい」は、どう生まれている?」といった多様なテーマから選ぶことができます。
自然とのつながりを大切に
TanKenのプログラムは、自然素材を利用した授業も特徴的です。たとえば、「土を通して、自分と世界はどうつながる?」というテーマでの授業では、土という素材を触れることでの感覚を大事にし、子どもたちが自ら表現を見つけ出す過程を大切にします。
最後に
「TanKen」は、ただ学ぶのではなく、自ら考え、問いを出し、実験を通じてその答えを見つける力を育む実験教室です。子どもたちの好奇心や探究心を大切にしながら、一緒に新しい発見をしていくことができる場となることを目指しています。ぜひ、多くの子どもたちに参加してもらい、未来の研究者やクリエイターを育てていきたいと思います。

トピックス(その他)










【記事の利用について】
タイトルと記事文章は、記事のあるページにリンクを張っていただければ、無料で利用できます。
※画像は、利用できませんのでご注意ください。
【リンクついて】
リンクフリーです。